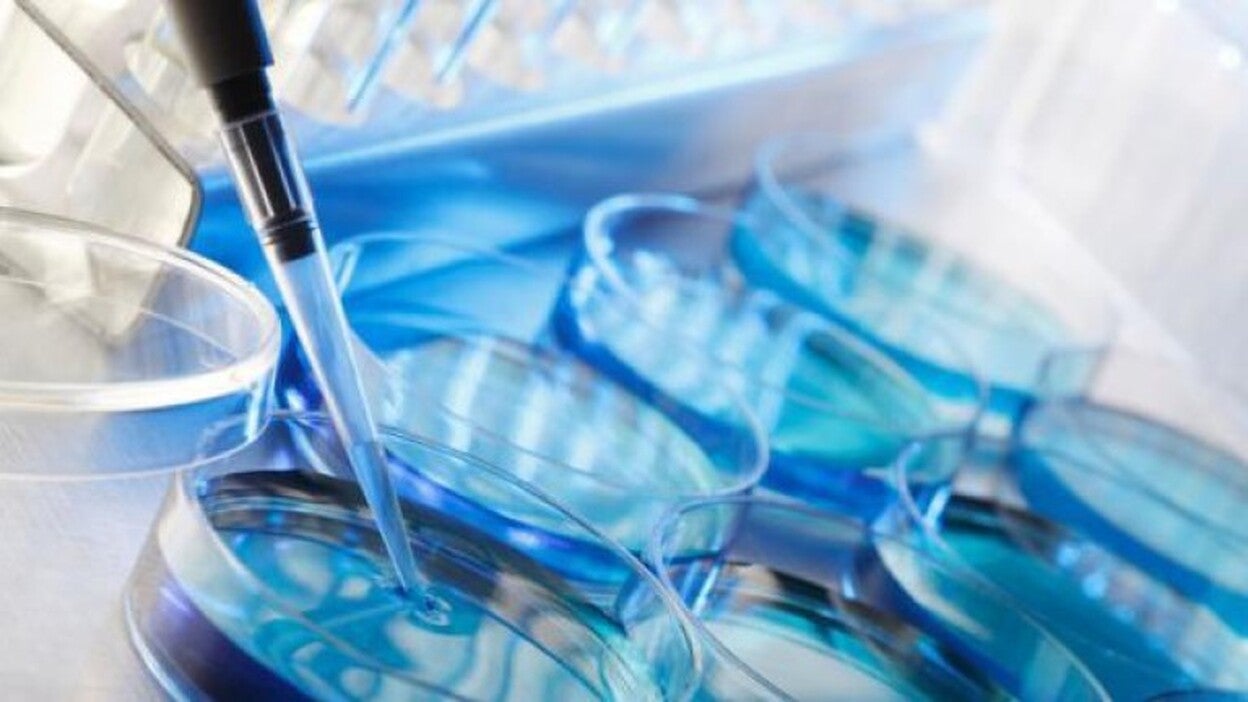
Crece la congelación de óvulos en España

Crece la congelación de óvulos en España
La congelación de óvulos ha aumentado un 65% en los últimos años en España, pasando de 2.174 vitrificaciones en 2009 a 3.601 en 2014, según los últimos datos de la Sociedad Española de Fertilidad, que ha vinculado este crecimiento a la tendencia de las mujeres españolas de retrasar la edad en la que tienen el primer hijo.
Europa Press / Barcelona
Viernes, 2 de junio 2017, 17:03
En un comunicado este viernes, con motivo del Día Mundial de la Fertilidad que se celebra el domingo, la Clínica Barcelona IVF ha explicado que la investigación y la innovación se centran actualmente en preservar la propia fertilidad, con el objetivo de evitar que las mujeres que quieren ser madres en una edad avanzada tengan que recurrir a donantes de óvulos.
En concreto, la edad media de las mujeres para ser madres en España ha aumentado hasta los 30,6 años, a la vez que la tasa de embarazo desciende a medida que pasan los años, ya que mientras que con 25 años las posibilidades de embarazo son de un 25% por ciclo, con 35 son del 12%, ha indicado la clínica, que ha añadido que los motivos económicos y laborales son las principales causas del retraso de la maternidad en España.
La técnica de la vitrificación, para preservar óvulos sanos, empezó a usarse en España hace 10 años, y actualmente puede realizarse en cualquier mujer, aunque se recomienda ser menor de 35 años, porque se calcula que pasados los 30 la reserva ovárica se sitúa en unos 100.000 ovocitos, ante el millón que se tiene al nacer y que se reduce progresivamente hasta la menopausia.
Pruebas gratuitas
La clínica ha impulsado la campaña ‘¿Se puede detener el reloj biológico?’ para proponer la conservación de los óvulos a mujeres que se planteen ser madres después de los 35, y durante una semana médicos especialistas realizarán pruebas gratuitas a mujeres para conocer su estado de fertilidad y sus posibilidades reproductivas.
Para congelar los óvulos, es necesario someterse antes a un proceso de estimulación ovárica a través de inyecciones y, cuando se hayan desarrollado suficientes folículos en los ovarios, se procede a la extracción por punción; es una técnica ambulatoria que se realiza con una sedación suave y tras la cual la paciente puede volver a casa.
En Cataluña, la donación de óvulos se ha multiplicado por diez en la última década, pasando de 1.340 a 11.700, según los datos estadísticos de reproducción asistida de la Conselleria de Salud de la Generalitat, ha indicado el centro médico.